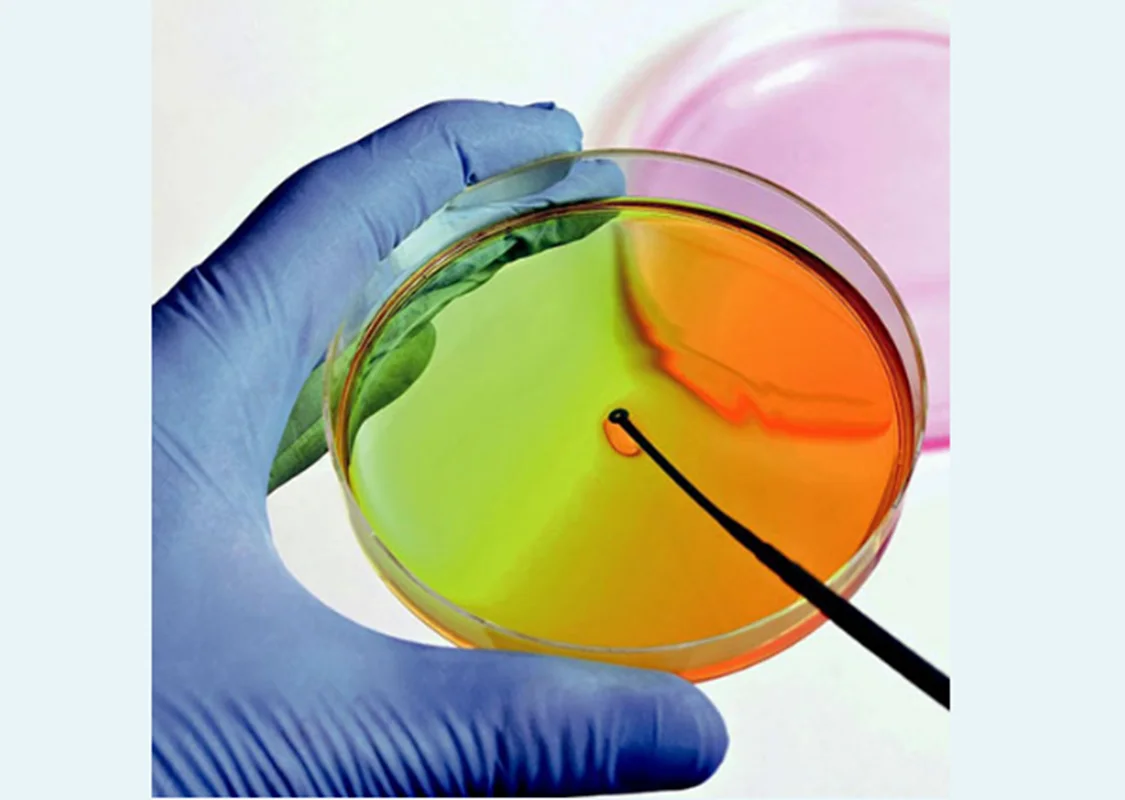
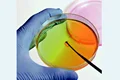

پلیت یا پتری دیش براساس نام مخترع آن، باکتری شناس آلمانی ژولیوس ریچارد پتری ( German bacteriologist Julius Richard Petri) گرفته شده است. از این وسیله زیست شناسان برای کشت سلولی استفاده می کنند.
محصولات مرتبط
پلیت کشت سلول صفحه ای مسطح است که تعداد مشخصی چاهک روی آن قرار دارد. این تعداد با توجه به نوع آزمایش و کشت سلول بستگی داشته و در تعداد 4،6،12،24،48،96 خانه وجود دارند. درب های این ظروف برای سهولت کار شماره گذاری شده و همچنین امکان عبور گاز از آن ها وجود دارد.
- شفافیت مناسب
- ته صاف، U شکل یا V شکل
- استریل و تیمار شده
- عدم دسترسی چاهک ها به یکدیگر و جلوگیری از آلودگی سلول ها
- کشت سلول در مقیاس های کوچک تا بزرگ
- کشت سلول در تعداد بالا و در فضایی محدود
- آزمایشگاه های تشخیص پزشکی در انسان و حیوان
- موجود در انواع مختلف از جمله 6 خانه ، 12خانه ، 24 خانه و 96 خانه

دیدگاه خود را بنویسید